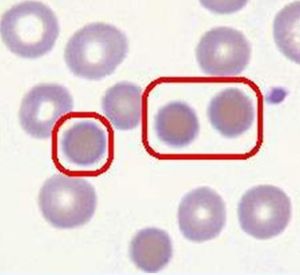
球形紅細胞
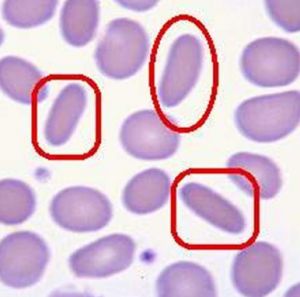
橢圓紅細胞
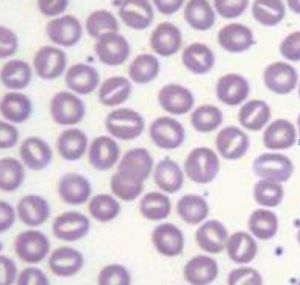
口形紅細胞
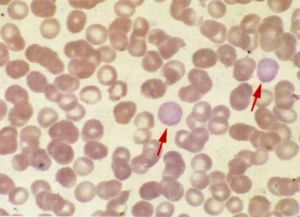
紅細胞中心淡染區輕度擴大

概述
 人類紅細胞膜的主要蛋白質
人類紅細胞膜的主要蛋白質人類紅細胞膜是由脂質雙層分子形成其基本結構,蛋白質鑲嵌在脂質雙層中或襯於其內側面。由於紅細胞膜脂質中脂肪酸不飽和程度高,脂質熔點低於正常體溫,使紅細胞呈液態,即脂質和蛋白質的分子可以在薄膜樣的結構內作側面移動,從而使膜和血漿中的脂質不斷進行交換,以維持膜指質的更新,襯於紅細胞脂質雙層內側面和多種蛋白質按一定規律形成柔韌的網路狀結構,並與脂質雙層密切聯繫起著支持和穩定脂質雙層的作用,維持著血紅細胞的表面積,雙凹盤形和變形性;還與其他膜蛋白保持紅細胞內外陽離子的梯度和水的平衡。當紅細胞膜上某種蛋白質的數量或結構發生變化,即可出現形態和功能異常,甚至發生溶血性貧血。如遺傳性球形紅細胞增多症、遺傳性橢圓形紅細胞增多症、遺傳性口形紅細胞增多症都是由於遺傳性膜缺陷所致。陣發性睡眠性血紅蛋白尿症則是後天性獲得性紅細胞膜缺陷症。
檢驗
 血液檢測
血液檢測紅細胞膜缺陷的檢驗包括紅細胞滲透脆性試驗、自身溶血試驗及其糾正試驗、酸化甘油溶血試驗、蔗糖溶血試驗、酸化血清溶血試驗、紅細胞膜蛋白電泳分析。
紅細胞滲透脆性試驗
原理:檢測紅細胞對不同濃度低滲鹽溶液的抵抗力。紅細胞在低滲鹽溶液中,當水滲透其內部達一定程度時,紅細胞發生膨脹破裂。根據不同濃度的低滲鹽溶液中紅細胞溶血的情況,通過紅細胞表面積與容積的比值,反映其對低滲鹽溶液的抵抗性。比值愈小,紅細胞抵抗力愈小,滲透脆性增加。反之抵抗力增大。
參考值:開始溶血0.44%~0.42%(NaCl液),完全溶血0.34%~0.32%(NaCl液)。
臨床意義:脆性增高見於遺傳性球形細胞增多症、橢圓形細胞增多症等;降低見於阻塞性黃疸、珠蛋白生成障礙性貧血、缺鐵性貧血等。
自身溶血試驗及其糾正試驗
原理:紅細胞在37℃孵育48小時,其間由於膜異常引起鈉內流傾向明顯增加,ATP消耗過多;或糖酵解途徑酶缺乏所引起ATP生成不足等原因可導致溶血,稱為自身溶血試驗。在孵育時,加入葡萄糖或ATP作為糾正物,觀察溶血可否有一定的糾正,稱為糾正試驗。
參考值:48小時內不加糾正物的溶血度小於3.5%,加葡萄糖溶血度小於1.0%,加ATP的溶血度小於l.0%
臨床意義:膜缺陷患者溶血度增加,加糾正物可被糾正;G6PD缺陷症者溶血度輕度增加,能被葡萄糖糾正;自身免疫性溶貧溶血度輕度增加,加葡萄糖無預示價值;PNH本試驗常正常。
酸化甘油溶血試驗
原理:當甘油存在於低滲溶液氯化鈉磷酸緩衝液時,可阻止其中的水快速進入紅細胞內,使溶血過程緩慢。但甘油與膜脂質又有親和性,可使膜脂質減少。當紅細胞膜蛋白及膜脂質有缺陷時,它們在pH6.85甘油緩衝液中比正常紅細胞溶解速度快,導致紅細胞懸液的吸光度降至50%的時間(AGLT50)明顯縮短。
參考值:AGLT50大於1800s(30min)
臨床意義:減少見於遺傳性球形細胞增多症(25~150s)、腎功能衰竭、慢性白血病、自身免疫性溶貧和妊娠婦女。
蔗糖溶血試驗
蔗糖溶血試驗為PNH簡易重要的篩查試驗。
原理:是根據PNH患者的紅細胞,在低離子強度的蔗糖溶液中對補體敏感性增強,經孵育,補體與紅細胞膜結合加強,蔗糖溶液進入紅細胞內,導致滲透性溶血而設計的。
參考值:定性試驗:正常為陰性;定量試驗:正常溶血率<5%。
臨床意義:PNH患者為陽性或溶血率增加,可作為PNH的篩選試驗。自免溶貧有的可為陽性,白血病、骨髓硬化時可出現假陽性。
酸化血清溶血試驗
原理:陣發性睡眠性血紅蛋白尿症(PNH)患者體記憶體在對補體敏感的紅細胞。酸化血清溶血試驗,也稱Hamtest,即紅細胞在
 紅細胞膜平鋪
紅細胞膜平鋪酸性(pH6.4~6.5)的正常血清中孵育,補體被激活,PNH紅細胞破壞而產生溶血。而正常紅細胞不被溶解,無溶血現象。
臨床意義:是PNH的確診試驗。陽性主要見於PNH,某些自身免疫性溶血性貧血發作嚴重時可呈陽性。
紅細胞膜蛋白電泳分析
原理:將製備的紅細胞膜樣品進行SDS-PAGE電泳,根據樣品中各蛋白相對分子質量的不同,分離得到紅細胞膜蛋白的電泳圖譜,從而可見各膜蛋白組分百分率。
參考值:各種膜蛋白組分百分率變化較大,多以正常紅細胞膜蛋白電泳圖譜作比較。或以帶3蛋白為基準,各膜蛋白含量以與帶3蛋白的比例表示。
臨床意義:許多溶血性疾病常見紅細胞膜蛋白異常。各種膜缺陷疾病如遺傳性球形紅細胞增多症有收縮蛋白等含量減低或結構異
常。某些血紅蛋白病骨架蛋白等可明顯異常。
相關疾病
遺傳性球形紅細胞增多症
球形紅細胞
球形紅細胞遺傳性球形紅細胞增多症是一種紅細胞膜先天缺陷的溶血性貧血,其特點為慢性溶血過程常伴有急性發作,循環血液中球形紅細胞增多,紅細胞滲透脆性增高,並有不同程度的脾腫大和黃疸。
遺傳規律
常染色體顯性遺傳,兩性患病率相等。少數可為常染色體隱性遺傳。
臨床分型
輕型:約占1/4,多見於兒童。
中間型:約占2/3,多見於成年人。
重型:少數病人貧血嚴重,常依賴輸血。
體徵:主要為脾腫大,肝臟一般可以觸及,並有程度不一的黃疸和貧血。
併發症
 紅細胞增生
紅細胞增生常因感染、妊娠及其他因素而誘發溶血危象,但一般不太嚴重;誘發再障危象,一般較兇險,重者甚至可以致死;此外,膽結石常多見的併發症,可出現阻塞性黃疸和感染的症狀。
實驗室檢查
血象:
外周血塗片球形紅細胞明顯增多
網織紅細胞計數增高,5%~10%
紅細胞參數MCV大多正常或輕度減低,
MCHC大多增高致35%~38%
紅細胞滲透脆性試驗:
增高,但有10%~20%的患者正常。
骨髓檢查:
紅細胞增生明顯,晚幼和中幼紅細胞增生可占骨髓有核細胞的25%~60%,核分裂多見。
再障危象時,骨髓中紅細胞顯著減少,粒巨細胞也減少,骨髓和外周血中網織紅細胞顯著減少。
其他檢查 :
血清間接膽紅素增多;糞膽原排泄明顯增高;尿膽原增高;血清鐵正常或增高;紅細胞生存時間明顯縮短。
治療:脾切除;輸血;再障危象治療
遺傳性橢圓形紅細胞增多症
橢圓紅細胞
橢圓紅細胞遺傳性橢圓形紅細胞增多症是一組高度異質性疾病。各亞型之間的臨床表現,紅細胞形態分子病理學等都有區別,但
共同特點是外周血中出現大量橢圓形、卵圓形或棒狀紅細胞,其中以橢圓形紅細胞為主,一般可高達50%~90%,國內學者提出超過25%就有診斷意義。
遺傳性橢圓形紅細胞增多症有家族遺傳史,大多數患者為常染色體顯性遺傳,少數為隱性遺傳。男女均可發病,多為雜合子,少數嚴重溶血者為純合子。
臨床分型
隱匿性:無症狀,無明顯溶血證據,為雜合子
溶血代償型:有慢性溶血,但紅細胞生成良好,無貧血,脾可輕度腫大
溶血性貧血型:有輕~中度貧血,間歇性黃疸和輕至;中度脾腫大,且在慢性溶血過程中可;發生膽石症和再生障
礙或溶血危象。國外報導隱匿型占85%,余兩型則在15%以內。
亞型
口形紅細胞
口形紅細胞輕度溶血型:可溶血及輕度貧血
偶發溶血型:只有在感染、妊娠時溶血加重,出現貧血
嚴重溶血型:為良性HE的純合子,出生後即出現溶血,紅細胞形態顯著異常,可見多數紅細胞碎片
嬰兒期溶血型:嬰兒期有中重度貧血,1歲後改善或消失
實驗室檢查
1.輕重不等的溶血性貧血的外周血和骨髓象改變,隱匿型可完全正常。
2.典型表現為外周血塗片可見多數橢圓形紅細胞,呈橢圓、棒狀或卵圓形多種形態,占紅細胞的25%以上。可伴有少數異形紅細胞或球形紅細胞。
3.少數兼有球形特徵的橢圓形紅細胞增多症,滲透脆性試驗和自身溶血試驗增高。
4.膜電泳檢查有助於確定膜分子病變。
鑑別診斷
1.不少貧血也可見到橢圓形紅細胞,但數量不多,但同時有顯著的各類異形紅細胞增多。
2.HE有溶血危象時,紅細胞形態不一,大小不等,橢圓形紅細胞相對減少,則須與非球形細胞性溶血性貧血相鑑別,做家族紅細胞形態觀察有助於鑑別。
遺傳性口形紅細胞增多症
遺傳性口形紅細胞增多症是一組較為罕見的常染色體顯性遺傳的慢性溶血性疾病,周圍血液中口形紅細胞增多,有輕重不等的溶血和陽性家族史。
基本病理改變
膜對陽離子通透性增高。
臨床表現
溶血輕重不一,輕者只有紅細胞口形變而無臨床表現,因此不易發現;重者除貧血外,可有黃疸、肝脾腫大等慢性溶貧的症狀和體徵。
實驗室檢查
血象:貧血一般輕微,血紅蛋白一般很少低於80~100g/L,網織紅細胞中度增高(10%~20%),MCV增高,MCHC降低,外周血片口形紅細胞可達10%~50%。
溶血試驗:紅細胞脆性增高,自身溶血試驗陽性,葡萄糖或ATP可糾正。
陣發性睡眠性血紅蛋白尿症
陣發性睡眠性血紅蛋白尿症是一種後天獲得性造血幹細胞基因突變引起的紅細胞膜異常的溶血性貧血。
本病異常的紅細胞起源於有缺陷的造血幹細胞,是一種克隆性疾病。
紅細胞中心淡染區輕度擴大
紅細胞中心淡染區輕度擴大由於紅細胞膜缺乏控制補體溶血的蛋白,使紅細胞對補體介導的溶血敏感而發生溶血性貧血,粒細胞和血小板也因膜異常易被補體或抗體溶解破壞。
睡眠中組織器官酸度增高可能為本病紅細胞破壞的適當環境。
診斷要點
1.發病隱襲,病程遷延,病情輕重不一
2.陣發性或加重發作性血紅蛋白尿是典型症狀
3.合併感染較為常見
4.實驗室檢查
 血紅蛋白尿發作期溶血性貧血加重
血紅蛋白尿發作期溶血性貧血加重血象:全血細胞減少,正色素性或低色素性貧血,多嗜紅細胞增高,網織紅細胞增高。血小板數常減少,也可正常。
骨髓象:增生多為活躍或明顯活躍,少數減低或重度減低。粒紅巨三系均增殖,或僅紅系增生好,粒或巨核系增生低下。
血液生化檢查:急性溶血時,可見非結合膽紅素升高,血漿游離血紅蛋白、高鐵血紅蛋白、乳酸脫氫酶均升高,而血漿結合珠蛋白和血鐵蛋白減少。
尿:血紅蛋白尿發作期,尿隱血試驗陽性,多數患者尿含鐵血黃素呈持續陽性。發作期常有輕度蛋白尿,尿膽原排泄輕度增加。
特異性溶血試驗:Ham試驗;蔗糖血試驗;蛇毒因子溶血試驗;熱溶血試驗
再障-PNH綜合徵
凡再障轉化為PNH,或PNH轉化為再障,或兼有兩病特徵者,均屬再障-PNH綜合徵。
 有核細胞增生明顯活躍
有核細胞增生明顯活躍為表明兩病發生先後,或兼有兩病特徵時,臨床表現以何者為主,可將綜合徵分為四種情況:
1.再障®PNH指原有肯定的再障,轉為可確定的PNH,再障的表現已不明顯。
2.PNH®再障指原有肯定的PNH,轉為明確的再障,PNH的表現已不明顯。
3.PNH伴有再障特徵指臨床及實驗室檢查所見均說明病情仍以PNH為主,但伴有一個或一個以上部位骨髓增生低下,巨核細胞減少,網織紅細胞不增高等再障表現者。
4.再障伴有PNH特徵指臨床及實驗室檢查所見均說明病情仍以再障為主,但伴有PNH的有關實驗室檢查結果陽性者。
臨床血液學檢測
| 血液一般檢測包括血液細胞成分的常規檢查、網織紅細胞檢測和紅細胞沉降率檢測。近年來由於血液學分析儀的廣泛套用,血液常規檢測的項目日益增多。本任務是關於臨床血液學檢測的相關詞條。 |

